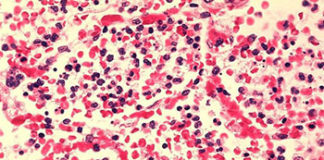
cjepivo lose bakterije

Oznaka: crijevne bakterije
Razvijeno novo cjepivo: uništava bakterije odgovorne za smrtonosnu upalu pluća, sepsu...
Cjepivo djeluje samo protiv loših bakterija i ne uništava one dobre u organizmu. Novo cjepivo daje obećavajuće rezultate u uništavanju bakterija...
Znanstvenici zabrinuti
Šokantni rezultati istraživanja. Korištenje antibiotika dva tjedna ili dulje može povećati rizik od raka crijeva za čak 73 posto! Izloženost antibioticima ranije u životu...